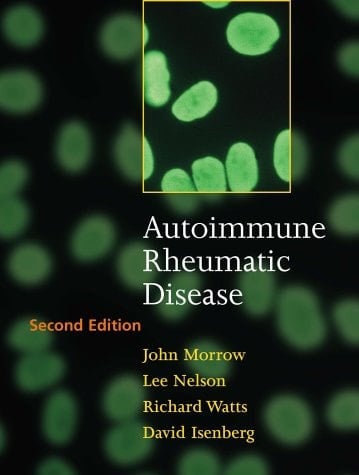
Autoimmune Rheumatic Disease

The book Autoimmune Rheumatic Disease (second edition) is a new fully revised edition of the award winning title. It fills the gap in the literature in that no other book bridges the divide between the clinical characterisation and treatment of autoimmune rheumatic diseases on the one hand and an understanding of laboratory-based research and disease pathogenesis on the other. This second edition is especially important because it describes and explains the advances in molecular biological techniques that have brought about major changes in understanding and also covers the new therapies which have been developed for many autoimmune rheumatic diseases.
Page Count:
277
Publication Date:
1999-04-15
No comments yet. Be the first to share your thoughts!